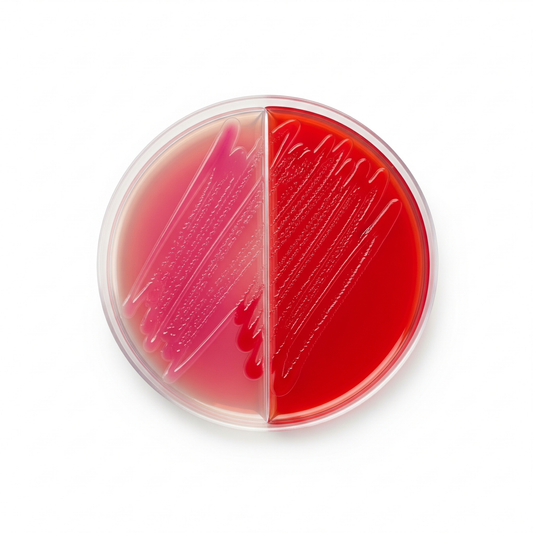

Collection: Products
-
Bile Esculin/BHI 6.5% NaCl Bi-plate 10/pk
Regular price $13.22 USDRegular priceUnit price / per -
Bio Molecular System Bluetooth Antenna Cable
Regular price $190.57 USDRegular priceUnit price / per -
Bio-Beads SX3
Regular price $1,015.63 USDRegular priceUnit price / per -
Biotin Assay Medium 100g
Regular price $89.58 USDRegular priceUnit price / per -
Bismuth Sulfite Agar Plate 10/pk
Regular price $20.61 USDRegular priceUnit price / per -
Blood Agar Base, 10 kg
Regular price $1,127.08 USDRegular priceUnit price / per -
Blood Agar Bi-plate 10/pk
Regular price $20.10 USDRegular priceUnit price / per -
Blood Agar Plates, 5% (2P-075) (10/PK)
Regular price $29.11 USDRegular priceUnit price / per -
Blood Agar Rodac Plate 10/pk
Regular price $30.52 USDRegular priceUnit price / per -
Blood Agar Slant 20/pk
Regular price $20.54 USDRegular priceUnit price / per -
BLOOD AGAR W/5% SUCROSE 10/PK
Regular price $24.84 USDRegular priceUnit price / per -
Blood Esculin Agar Plate 10/pk
Regular price $12.50 USDRegular priceUnit price / per -
Blood/EMB Bi-plate 10/pk
Regular price $42.55 USDRegular priceUnit price / per -
Blood/MAC Bi-Plate 10/pk
Regular price $42.55 USDRegular priceUnit price / per -
Bolton's Broth 2X, (90 ML) Flip Top, EA
Regular price $14.35 USDRegular priceUnit price / per -
Bottle Wide Glass 120mL CS24
Regular price $46.88 USDRegular priceUnit price / per